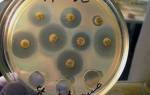

Записаться на прием в нашу клинику урологии – правильное решение
Урология «Логон — ас «- это клиника урологии со стажем. Здесь вам окажут должное внимание, профессиональный подход и современные схемы лечения урологических заболеваний.
Почему правильное? Если возникла такая мысль, значит, для нее есть поводы. В большинстве случаев обращение к урологу выполняется не сразу, а с задержкой. И зря, потому что затягивание болезни грозит осложнениями. Даже в том случае, когда подозрения не оправдались – получается, что Вы напрасно долго волновались.
Кроме того, все опасения и страхи быстро рассеиваются, как только вы пообщаетесь с врачом. Ведь сегодня существует множество современных способ лечения любой болезни, главное, прийти и все выяснить. В клинике урологии «Логон — Ас» выполняется точная ДНК-диагностика, наши врачи проводят обследования и лечат пациентов быстро, безболезненно и с очень хорошими результатами.
Врачи, работающие в области гинекологии и урологии в Москве, отмечают, что уровень медицинских услуг в этих направлениях значительно возрос за последние годы. Специалисты подчеркивают важность регулярных профилактических осмотров, которые помогают выявить заболевания на ранних стадиях. Они также акцентируют внимание на необходимости индивидуального подхода к каждому пациенту, что позволяет более точно диагностировать и эффективно лечить различные патологии.
Кроме того, врачи говорят о важности современных технологий, таких как минимально инвазивные методы лечения, которые снижают риск осложнений и сокращают время восстановления. Они рекомендуют пациентам не откладывать визит к специалисту при появлении тревожных симптомов и активно интересоваться своим здоровьем. В целом, врачи уверены, что грамотное взаимодействие между пациентом и врачом является ключом к успешному лечению и поддержанию здоровья.

Где найти хорошего гинеколога-уролога в Москве?
Наиболее часто встречающимися заболеваниями мочеполовой системы у женщин являются:
- Недержание мочи: Спектр различных заболеваний, вызывающих недержание мочи у женщин.
- Урогенитальные расстройства: Заболевания женской мочеполовой системы, вызывающие тазовые боли и дискомфорт
- Цистит: Воспаление мочевого пузыря, вызывающее боли при мочеиспускании.
- Уретрит: Заболевание уретры (мочевыводящего канала), также вызывающее боли при мочеиспускании
Если Вам нужен действительно хороший гинеколог — уролог, мы предлагаем вам воспользоваться услугами нашего медицинского центра по следующим причинам:
- Опытные врачи. Наш центр работает на московском рынке уже более 15 лет. Гинекология является одним из основных направлений нашей работы. В нашей клинике работают только опытные гинекологи, кандидаты и доктора наук, которые проходят тщательный профессиональный отбор.
- Новейшее оборудование и материалы. В нашем медицинском центре мы используем только новейшее оборудование и лабораторные материалы, отвечающие всем утвержденным стандартам качества.
- Прозрачность работы. Лечащий врач до лечения полностью расскажет вам, какие исследования и анализы будет необходимо провести, что будет происходить и какой ожидается результат.
- Экономия времени. Мы ценим ваше время, поэтому всегда заранее согласием с вами время последующего приема, чтобы вам не пришлось ждать.
При последующем лечении консультация гинеколога в нашей клинике делается БЕСПЛАТНО.
Также у нас всегда есть действующие СПЕЦПРЕДЛОЖЕНИЯ и СКИДКИ.
Позвоните нам, чтобы получить более детальную консультацию и записаться на прием по телефону 7 495 433 6777 и 7 495 433 1689 с 8 до 20 часов ежедневно.
Москва, метро Юго-Западная, Беляево или Коньково, ул. 26 Бакинских комиссаров, д. 6.
Записаться
Основные принципы работы клиники урологии «Логон — Ас»
1. Качественно и надежно. Вы получаете лечение с применением современных и надежных методов диагностики: УЗИ, лабораторная диагностика, ДНК-диагностика.2. Безопасно. Вы получаете лечение у врачей высшей категории, которые ежегодно повышают квалификацию в лучших учебных центрах России и Европы.
Москвичи активно обсуждают качество медицинских услуг в области гинекологии и урологии. Многие пациенты отмечают высокий уровень профессионализма врачей, которые не только обладают необходимыми знаниями, но и проявляют чуткость к пациентам. В клиниках столицы доступны современные методы диагностики и лечения, что вызывает доверие у пациентов. Однако некоторые жалуются на очереди и высокие цены на услуги. В то же время, многие отмечают, что индивидуальный подход и внимательное отношение врачей оправдывают затраты. В целом, отзывы о гинекологии и урологии в Москве разнообразны, но большинство людей ценят возможность получить квалифицированную помощь в комфортной обстановке.

Лечение в Центре женской урологии
-
медикаментозное лечение;
-
биологическая обратная связь — это интенсивная терапия, которая проводится еженедельно в условиях медицинского учреждения специально обученным медицинским персоналом в обязательном сочетании с упражнениями Кегеля дома;
-
электростимуляция — это наиболее сложный вид терапии обратной связи, который направлен на реабилитацию мышц тазового дна. Этот вид физиотерапии стимулирует мышцы, поднимающие задний проход, при помощи специальных электрических датчиков;
-
оперативное вмешательство: установке искусственного сфинктера мочевого пузыря при недержании мочи, пластика и реконструкция тазового дна при пролапсе.
Острые и хронические болезни мочевыделительной системы
Мы лечим как мужские и женские урологические болезни, так и общие (мочекаменная болезнь, почечная колика). Лечение урологических заболеваний у мужчин является одним из ключевых направлений в работе клиники Логон. Лечение всех болезней осуществляется по лучшим зарекомендованным годами и опытом методикам с применением самых современных и точных методов диагностики.
Мужчские болезни, связанные с урологией с гарантией положительного результата. Это такие заболевания как:
- заболевания передаваемые половым путем (гарантия результата)
- простатит, аденома простаты (предстательная железа)
- уретрит (мочеиспускательный канал)
- цистит (мочевой пузырь)
- баланопостит (головка и внутренний листок крайней плоти)
- орхит (яичко)
- эпидидимит (придаток яичка)
- мужское бесплодие
- рак
- восстановление потенции
- мужское бесплодие (ведение пар)
- сексология и сексопатология (решение проблем сексуальных расстройств) анонимно.
Женские урлогические заболевания:
Вопрос-ответ

Какие услуги предоставляет гинеколог в Москве?
Гинекологи в Москве предлагают широкий спектр услуг, включая профилактические осмотры, диагностику и лечение заболеваний репродуктивной системы, консультации по вопросам контрацепции, беременности и менопаузы, а также проведение ультразвуковых исследований и лабораторных анализов.
Как выбрать хорошего уролога в Москве?
При выборе уролога в Москве стоит обратить внимание на квалификацию врача, его опыт работы, отзывы пациентов и наличие современных методов диагностики и лечения. Также полезно уточнить, какие услуги предоставляет клиника и есть ли возможность пройти комплексное обследование.
Сколько стоит консультация гинеколога или уролога в Москве?
Стоимость консультации гинеколога или уролога в Москве может варьироваться в зависимости от клиники и уровня специалиста. В среднем, цена колеблется от 1500 до 5000 рублей. Рекомендуется уточнять стоимость заранее и спрашивать о возможных скидках или акциях.
Советы
СОВЕТ №1
Перед посещением гинеколога или уролога в Москве, подготовьте список вопросов, которые вас беспокоят. Это поможет вам не забыть важные моменты и получить исчерпывающие ответы на все интересующие вас темы.
СОВЕТ №2
Изучите отзывы о врачах и клиниках, чтобы выбрать специалиста с хорошей репутацией. Обратите внимание на опыт работы врача и наличие необходимых сертификатов и лицензий.
СОВЕТ №3
Не стесняйтесь задавать вопросы о процедурах и методах лечения, которые вам предлагают. Понимание процесса поможет вам чувствовать себя более уверенно и комфортно во время визита.
СОВЕТ №4
Регулярно проходите профилактические осмотры у гинеколога и уролога, даже если вас ничего не беспокоит. Это поможет выявить возможные проблемы на ранней стадии и сохранить ваше здоровье.